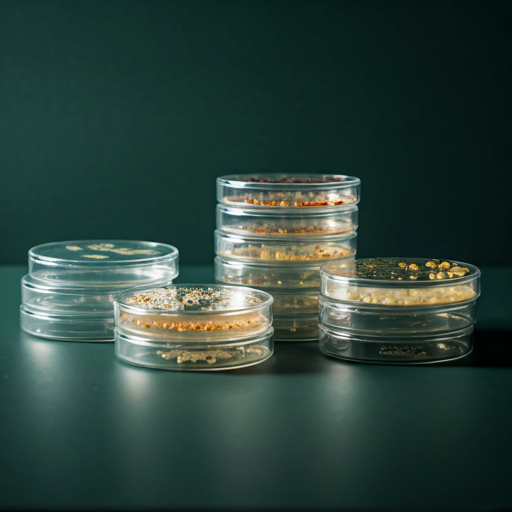

INTRODUCING
Divi Optimize Floating Images Module
The Floating Images module is a visually engaging component of the Divi Optimizer plugin, designed to add smooth, floating image effects to your Divi-built websites. With this module, you can showcase multiple images with subtle motion that creates depth and visual interest without overwhelming the layout.

Design #02: Minimalist Float Grid



Design #03: Serene Cascade

Design #04: The Orbit






Design #05: Dark Mode Drift




Design #06: Diagonal Flow






